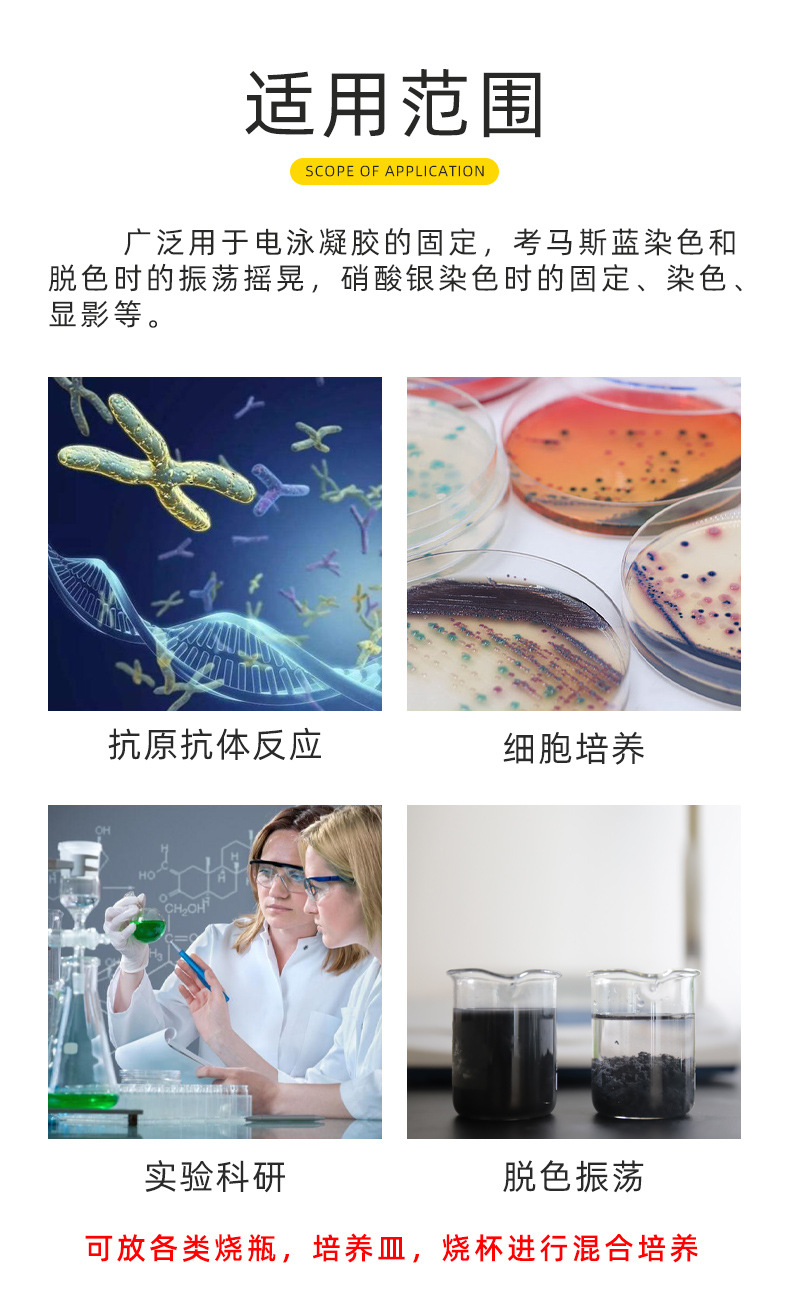
undefined

Генератор лабораторного уровня коромысло Шейкер Ротатор PRP качающаяся машина TM шейкер для обесцвечивания
Вес:
1.00 кг
Продано за 30 дней:
1 шт.
Всего продаж:
637 шт.
Минимальное количество для заказа:
1 шт.
Генератор лабораторного уровня коромысло Шейкер Ротатор PRP качающаяся машина TM шейкер для обесцвечивания
от 4 875.00 ₽ за 1 шт.
-21%
4 875.00 ₽
Доставка по Китаю включена в цену
Оптом
от 1 шт.
4 875.00 ₽
Описание
|

Характеристики
Происхождение:
Чанчжоу, Цзянсу
Ли импортировать:
Нет
Приказ №.:
Нет
Амплитуда шимми:
Посмотреть детали
Пункт Нет.:
Нет
Размеры:
Посмотреть детали
Диапазон времени:
Посмотреть детали
Настройка обработки:
Нет
Тип:
Посмотреть детали
Марка:
Jtliangjou
Объем:
Посмотреть детали
Диапазон регулирования температуры:
Посмотреть детали
Модель:
ТМС
Частота вращения:
Посмотреть детали
Вес:
Посмотреть детали
Технические характеристики:
TSM-180; TSM-180pro; TSM-180C модель зарядки; TSM-180T бесщеточный бесшумный Тип-(без ЖК-дисплея); TSM-180T бесщеточный бесшумный тип (ЖК-дисплей); TSM-90; TSM-90C; Ценники включают обычные билеты, специальные билеты необходимо добавить 12 баллов.
Является ли источник трансграничного экспорта исключительным:
Нет
О продавце
Имя:
Оценка сервиса:
4.5
Оценка логистики:
3.0
Оценка споров и жалоб:
5.0
Оценка предложения:
5.0
Оценка консультации:
3.0
repeatPurchasePercent:
0.48481583375329834
afterSalesExperienceScore:
4.7
qualityRefundWithin30Day:
0.0
Генератор лабораторного уровня коромысло Шейкер Ротатор PRP качающаяся машина TM шейкер для обесцвечивания
4 875.00 ₽
4 875.00 ₽
Курс юаня: 12.5









